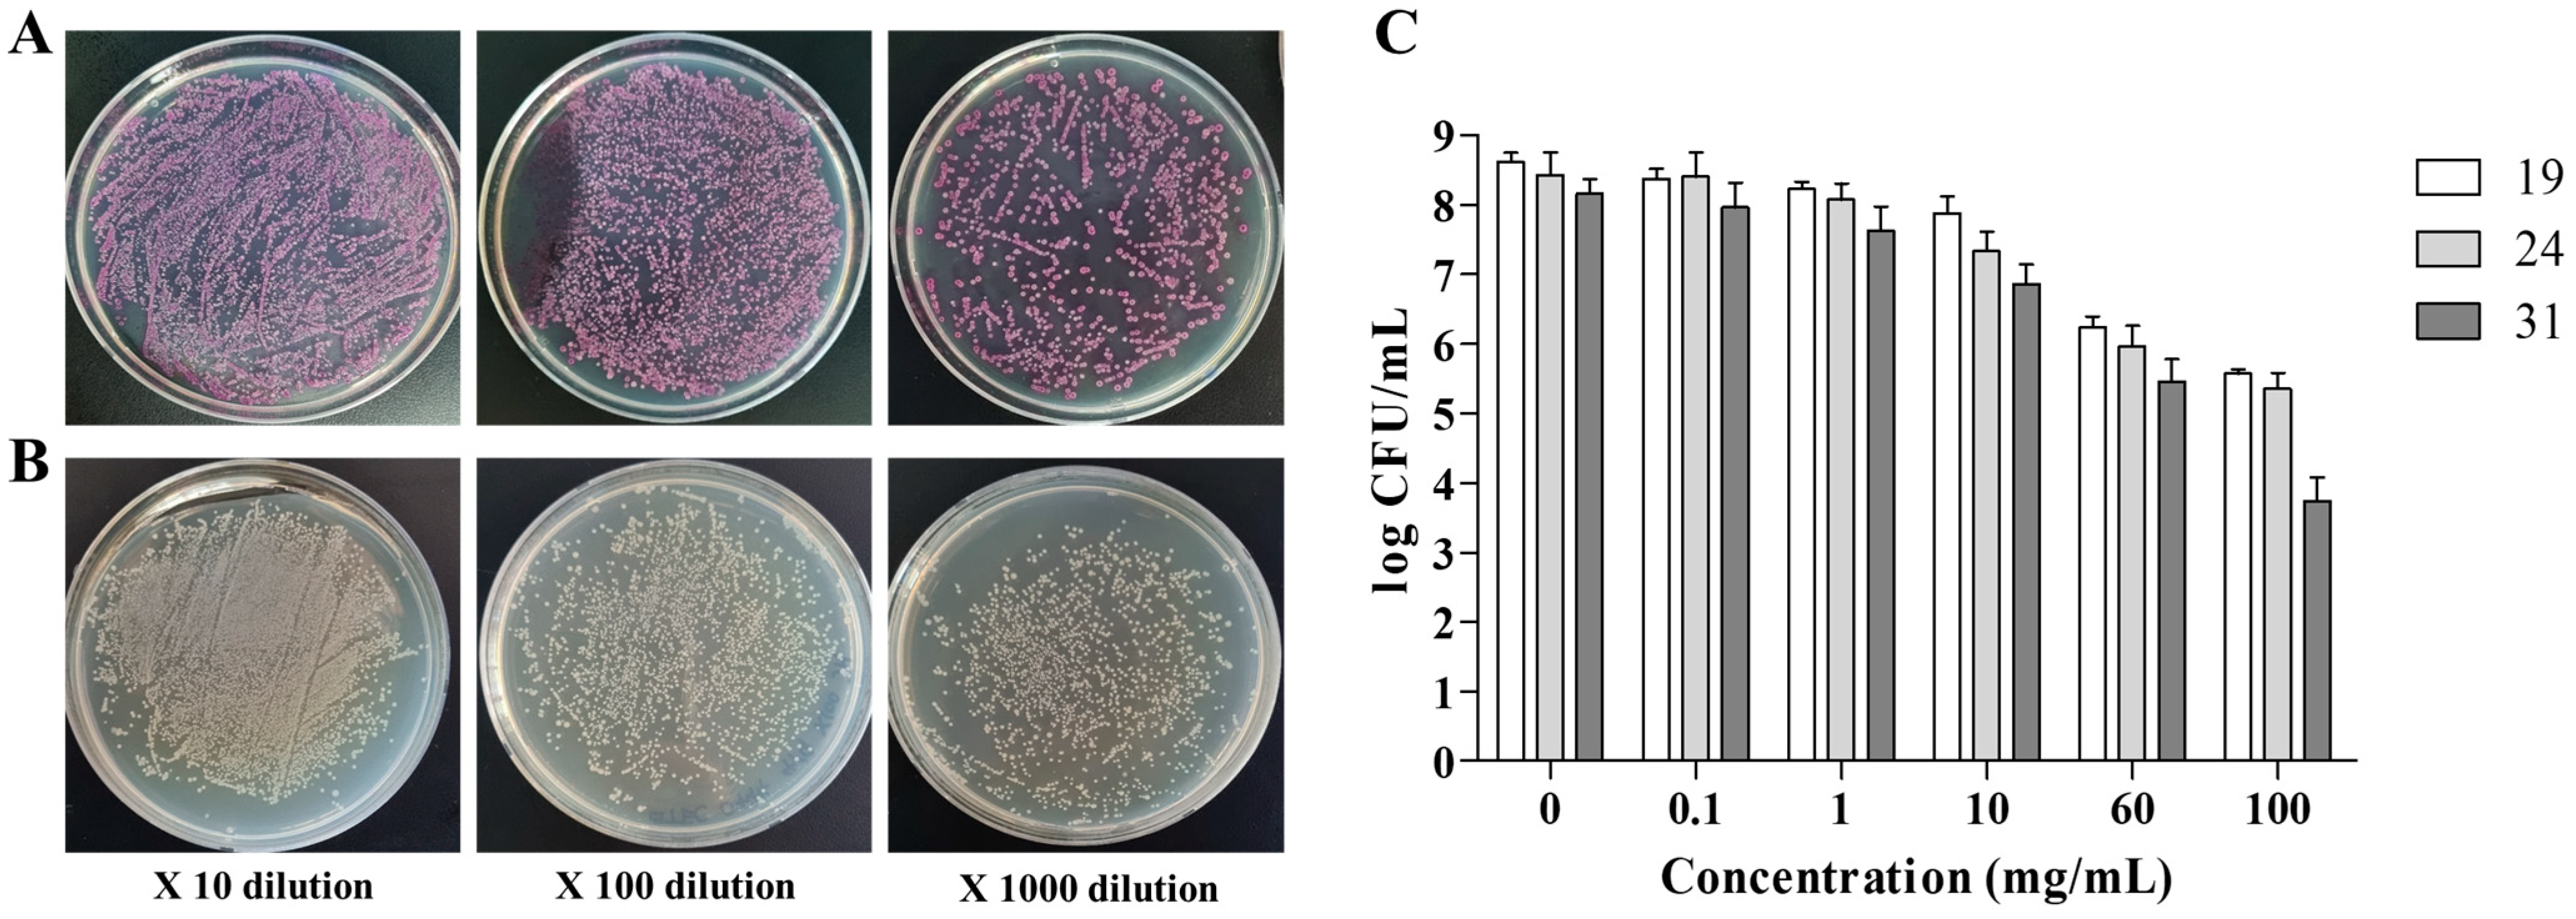
Pathogens 10 01573 g002 Pathogens 10 01573 g002

Prophylactic Catechin-Rich Green Tea Extract Treatment Ameliorates Pathogenic Enterotoxic Escherichia coli-Induced Colitis
Abstract
1. Introduction
2. Results
2.1. Catechin Content in the GTE
2.2. Antibacterial Effect of GTE against Pathogenic E. coli
2.3. Effect of GTE on Pathogenic E. coli-Induced Intestinal Injury
2.4. Effect of GTE on Pathogenic E. coli-Induced Alterations in the Jejunum
2.5. Effect of GTE on Annexin A1 Expression in Pathogenic E. coli-Challenged Mice Intestine
2.6. Effect of GTE on Inflammation and Proliferation-Related Signal Expression
3. Discussion
4. Materials and Methods
4.1. GTE Preparation
4.2. HPLC Analysis
4.3. Antibacterial Activity Assessment
4.4. Animal Study
4.5. Histopathological Analyses
4.6. Western Blot Analysis
4.7. IHC Analysis
4.8. Statistical Analyses
5. Conclusions
Author Contributions
Funding
Institutional Review Board Statement
Informed Consent Statement
Data Availability Statement
Conflicts of Interest
References
- Rowland, I.; Gibson, G.; Heinken, A.; Scott, K.; Swann, J.; Thiele, I.; Tuohy, K. Gut microbiota functions: Metabolism of nutrients and other food components. Eur. J. Nutr. 2018, 57, 1–24. [Google Scholar] [CrossRef]
- Nataro, J.P.; Kaper, J.B. Diarrheagenic Escherichia coli. Clin. Microbiol. Rev. 1998, 11, 142–201. [Google Scholar] [CrossRef]
- Quah, S. International Encyclopedia of Public Health, 2nd ed.; Academic Press: Cambridge, MA, USA, 2016; pp. 99–100. [Google Scholar]
- Kaper, J.B.; Nataro, J.P.; Mobley, H.L. Pathogenic Escherichia coli. Nat. Rev. Microbiol. 2004, 2, 123–140. [Google Scholar] [CrossRef]
- Clements, A.; Young, J.C.; Constantinou, N.; Frankel, G. Infection strategies of enteric pathogenic Escherichia coli. Gut Microbes 2012, 3, 71–87. [Google Scholar] [CrossRef] [PubMed]
- Ledwaba, S.E.; Costa, D.V.; Bolick, D.T.; Giallourou, N.; Medeiros, P.H.; Swann, J.R.; Traore, A.N.; Potgieter, N.; Nataro, J.P.; Guerrant, R.L. Enteropathogenic Escherichia coli Infection Induces Diarrhea, Intestinal Damage, Metabolic Alterations, and Increased Intestinal Permeability in a Murine Model. Front. Cell. Infect. Microbiol. 2020, 10, 772. [Google Scholar] [CrossRef]
- Parente, L.; Solito, E. Annexin 1: More than an anti-phospholipase protein. Inflamm. Res. 2004, 53, 125–132. [Google Scholar] [CrossRef]
- Cahill, S.M.; Desmarchelier, P.; Fattori, V.; Bruno, A.; Cannavan, A. Global perspectives on antimicrobial resistance in the food chain. Food Prot. Trends 2017, 37, 353–360. [Google Scholar]
- Pancu, D.F.; Scurtu, A.; Macasoi, I.G.; Marti, D.; Mioc, M.; Soica, C.; Coricovac, D.; Horhat, D.; Poenaru, M.; Dehelean, C. Antibiotics: Conventional Therapy and Natural Compounds with Antibacterial Activity—A Pharmaco-Toxicological Screening. Antibiotics 2021, 10, 401. [Google Scholar] [CrossRef]
- Sharangi, A.B. Medicinal and therapeutic potentialities of tea (Camellia sinensis L.)—A review. Food Res. Int. 2009, 42, 529–535. [Google Scholar] [CrossRef]
- Reygaert, W.C. Green tea catechins: Their use in treating and preventing infectious diseases. BioMed Res. Int. 2018, 2018, 9105261. [Google Scholar] [CrossRef] [PubMed]
- Hodges, J.K.; Zhu, J.; Yu, Z.; Vodovotz, Y.; Brock, G.; Sasaki, G.Y.; Dey, P.; Bruno, R.S. Intestinal-level anti-inflammatory bioactivities of catechin-rich green tea: Rationale, design, and methods of a double-blind, randomized, placebo-controlled crossover trial in metabolic syndrome and healthy adults. Contemp. Clin. Trials Commun. 2020, 17, 100495. [Google Scholar] [CrossRef] [PubMed]
- Marinovic, M.P.; Morandi, A.C.; Otton, R. Green tea catechins alone or in combination alter functional parameters of human neutrophils via suppressing the activation of TLR-4/NFκB p65 signal pathway. Toxicol. In Vitro 2015, 29, 1766–1778. [Google Scholar] [CrossRef] [PubMed]
- Hoshino, N.; Kimura, T.; Yamaji, A.; Ando, T. Damage to the cytoplasmic membrane of Escherichia coli by catechin-copper (II) complexes. Free Radic. Biol. Med. 1999, 27, 1245–1250. [Google Scholar] [CrossRef]
- Sugita-Konishi, Y.; Hara-Kudo, Y.; Amano, F.; Okubo, T.; Aoi, N.; Iwaki, M.; Kumagai, S. Epigallocatechin gallate and gallocatechin gallate in green tea catechins inhibit extracellular release of Vero toxin from enterohemorrhagic Escherichia coli O157:H7. Biochim. Biophys. Acta 1999, 1472, 42–50. [Google Scholar] [CrossRef]
- Cho, Y.S.; Schiller, N.L.; Kahng, H.Y.; Oh, K.H. Cellular responses and proteomic analysis of Escherichia coli exposed to green tea polyphenols. Curr. Microbiol. 2007, 55, 501–506. [Google Scholar] [CrossRef] [PubMed]
- Kumar, A.; Kumar, A.; Thakur, P.; Patil, S.; Payal, C.; Kumar, A.; Sharma, P. Antibacterial activity of green tea (Camellia sinensis) extracts against various bacteria isolated from environmental sources. Recent Res. Sci. Technol. 2012, 4, 19–23. [Google Scholar]
- Reygaert, W.; Jusufi, I. Green tea as an effective antimicrobial for urinary tract infections caused by Escherichia coli. Front. Microbiol. 2013, 4, 162. [Google Scholar] [CrossRef] [PubMed]
- Ikigai, H.; Nakae, T.; Hara, Y.; Shimamura, T. Bactericidal catechins damage the lipid bilayer. Biochim. Biophys. Acta 1993, 1147, 132–136. [Google Scholar] [CrossRef]
- Chang, E.H.; Huang, J.; Lin, Z.; Brown, A.C. Catechin-mediated restructuring of a bacterial toxin inhibits activity. Biochim. Biophys. Acta Gen. Subj. 2019, 1863, 191–198. [Google Scholar] [CrossRef]
- Arakawa, H.; Maeda, M.; Okubo, S.; Shimamura, T. Role of hydrogen peroxide in bactericidal action of catechin. Biol. Pharm. Bull. 2004, 27, 277–281. [Google Scholar] [CrossRef] [PubMed]
- Nakayama, M.; Shimatani, K.; Ozawa, T.; Shigemune, N.; Tomiyama, D.; Yui, K.; Katsuki, M.; Ikeda, K.; Nonaka, A.; Miyamoto, T. Mechanism for the antibacterial action of epigallocatechin gallate (EGCg) on Bacillus subtilis. Biosci. Biotechnol. Biochem. 2015, 79, 845–854. [Google Scholar] [CrossRef] [PubMed]
- Partouche, D.; Turbant, F.; El Hamoui, O.; Campidelli, C.; Bombled, M.; Trépout, S.; Wien, F.; Arluison, V. Epigallocatechin Gallate Remodelling of Hfq Amyloid-Like Region Affects Escherichia coli Survival. Pathogens 2018, 7, 95. [Google Scholar] [CrossRef] [PubMed]
- Liu, X.; Shen, B.; Du, P.; Wang, N.; Wang, J.; Li, J.; Sun, A. Transcriptomic analysis of the response of Pseudomonas fluorescens to epigallocatechin gallate by RNA-seq. PLoS ONE 2017, 12, e0177938. [Google Scholar] [CrossRef]
- Kitichalermkiat, A.; Katsuki, M.; Sato, J.; Sonoda, T.; Masuda, Y.; Honjoh, K.I.; Miyamoto, T. Effect of epigallocatechin gallate on gene expression of Staphylococcus aureus. J. Glob. Antimicrob. Resist. 2020, 22, 854–859. [Google Scholar] [CrossRef]
- Stapleton, P.D.; Shah, S.; Anderson, J.C.; Hara, Y.; Hamilton-Miller, J.M.; Taylor, P.W. Modulation of beta-lactam resistance in Staphylococcus aureus by catechins and gallates. Int. J. Antimicrob. Agents 2004, 23, 462–467. [Google Scholar] [CrossRef]
- Wu, M.; Brown, A.C. Applications of Catechins in the Treatment of Bacterial Infections. Pathogens 2021, 10, 546. [Google Scholar] [CrossRef]
- Singh, B.N.; Shankar, S.; Srivastava, R.K. Green tea catechin, epigallocatechin-3-gallate (EGCG): Mechanisms, perspectives and clinical applications. Biochem. Pharmacol. 2011, 82, 1807–1821. [Google Scholar] [CrossRef] [PubMed]
- Jazani, N.H.; Zartoshti, M.; Shahabi, S.; Yekta, Z.; Nateghi, S. Evaluation of the synergetic effect of water soluble extracts of green tea (Camellia sinensis) on the activity of ciprofloxacin in urinary isolated E. coli. J. Biol. Sci. 2007, 7, 1500–1503. [Google Scholar] [CrossRef][Green Version]
- Neyestani, T.R.; Khalaji, N.; Gharavi, A.A. Selective microbiologic effects of tea extract on certain antibiotics against Escherichia coli in vitro. JACM 2007, 13, 1119–1124. [Google Scholar] [CrossRef]
- Luissint, A.C.; Parkos, C.A.; Nusrat, A. Inflammation and the intestinal barrier: Leukocyte–epithelial cell interactions, cell junction remodeling, and mucosal repair. Gastroenterology 2016, 151, 616–632. [Google Scholar] [CrossRef]
- Leoni, G.; Nusrat, A. Annexin A1: Shifting the balance towards resolution and repair. Biol. Chem. 2016, 397, 971–979. [Google Scholar] [CrossRef]
- Sugimoto, M.A.; Vago, J.P.; Teixeira, M.M.; Sousa, L.P. Annexin A1 and the resolution of inflammation: Modulation of neutrophil recruitment, apoptosis, and clearance. J. Immunol. Res. 2016, 2016, 8239258. [Google Scholar] [CrossRef]
- de Paula-Silva, M.; Barrios, B.E.; Macció-Maretto, L.; Sena, A.A.; Farsky, S.H.P.; Correa, S.G.; Oliani, S.M. Role of the protein annexin A1 on the efficacy of anti-TNF treatment in a murine model of acute colitis. Biochem. Pharmacol. 2016, 115, 104–113. [Google Scholar] [CrossRef]
- da Rocha, G.H.O.; de Paula-Silva, M.; Broering, M.F.; Scharf, P.R.D.S.; Matsuyama, L.S.A.S.; Maria-Engler, S.S.; Farsky, S.H.P. Pioglitazone-Mediated Attenuation of Experimental Colitis Relies on Cleaving of Annexin A1 Released by Macrophages. Front. Pharmacol. 2020, 11, 591561. [Google Scholar] [CrossRef]
- Babbin, B.A.; Laukoetter, M.G.; Nava, P.; Koch, S.; Lee, W.Y.; Capaldo, C.T.; Peatman, E.; Severson, E.A.; Flower, R.J.; Perretti, M.; et al. Annexin A1 regulates intestinal mucosal injury, inflammation, and repair. J. Immunol. 2008, 181, 5035–5044. [Google Scholar] [CrossRef] [PubMed]
- Serhan, C.N.; Chiang, N.; Van Dyke, T.E. Resolving inflammation: Dual anti-inflammatory and pro-resolution lipid mediators. Nat. Rev. Immunol. 2008, 8, 349–361. [Google Scholar] [CrossRef]
- Buckley, C.D.; Gilroy, D.W.; Serhan, C.N. Pro-resolving lipid mediators and mechanisms in the resolution of acute inflammation. Immunity 2014, 40, 315–327. [Google Scholar] [CrossRef] [PubMed]
- Kolios, G.; Valatas, V.; Ward, S.G. Nitric oxide in inflammatory bowel disease: A universal messenger in an unsolved puzzle. Immunology 2004, 113, 427–437. [Google Scholar] [CrossRef]
- Savkovic, S.D.; Villanueva, J.; Turner, J.R.; Matkowskyj, K.A.; Hecht, G. Mouse model of enteropathogenic Escherichia coli infection. Infect. Immun. 2005, 73, 1161–1170. [Google Scholar] [CrossRef] [PubMed]
- Wang, T.; Teng, K.; Liu, G.; Liu, Y.; Zhang, J.; Zhang, X.; Zhang, M.; Tao, Y.; Zhong, J. Lactobacillus reuteri HCM2 protects mice against Enterotoxigenic Escherichia coli through modulation of gut microbiota. Sci. Rep. 2018, 8, 17485. [Google Scholar] [CrossRef]
- Allen, K.P.; Randolph, M.M.; Fleckenstein, J.M. Importance of heat-labile enterotoxin in colonization of the adult mouse small intestine by human enterotoxigenic Escherichia coli strains. Infect. Immun. 2006, 74, 869–875. [Google Scholar] [CrossRef] [PubMed]
- Lewis, S.B.; Cook, V.; Tighe, R.; Schüller, S. Enterohemorrhagic Escherichia coli colonization of human colonic epithelium in vitro and ex vivo. Infect. Immun. 2015, 83, 942–949. [Google Scholar] [CrossRef]
- Wang, K.; Qi, Y.; Yi, S.; Pei, Z.; Pan, N.; Hu, G. Mouse duodenum as a model of inflammation induced by enterotoxigenic Escherichia coli K88. J. Vet. Res. 2016, 60, 19–23. [Google Scholar] [CrossRef]
- Umar, S. Intestinal stem cells. Curr. Gastroenterol. Rep. 2010, 12, 340–348. [Google Scholar] [CrossRef] [PubMed]
- Bonis, V.; Carla, R.; Helmuth, G. The intestinal epithelium–fluid fate and rigid structure from crypt bottom to villus tip. Front. Cell Dev. Biol. 2021, 9, 661931. [Google Scholar] [CrossRef]
- Ko, J.W.; Shin, N.R.; Park, S.H.; Lee, I.C.; Ryu, J.M.; Kim, H.J.; Cho, Y.K.; Kim, J.C.; Shin, I.S. Silibinin inhibits the fibrotic responses induced by cigarette smoke via suppression of TGF-β1/Smad 2/3 signaling. Food Chem. Toxicol. 2017, 106 Pt A, 424–429. [Google Scholar] [CrossRef]

| Compound | Pathogens | Signals (Marker) | References |
|---|---|---|---|
| Epigallocatechin | Escherichia coli; Escherichia coli O157:H7; Escherichia coli; Pseudomonas aeruginosa; Escherichia coli | ATP and potassium pool; Verotoxin; Cellular defense protein; Antibacterial Susceptibility; Antibacterial Susceptibility | [14,15,16,17,18] |
| Epicatechin | Escherichia coli; Escherichia coli O157:H7; Escherichia coli; Pseudomonas aeruginosa; Escherichia coli; Gram-positive bacteria; Aggregatibacter actinomycetemcomitans | ATP and potassium pool; Verotoxin; Cellular defense protein; Antibacterial Susceptibility; Antibacterial Susceptibility; Bacterial membrane; Leukotoxin activity | [14,15,16,17,18,19,20] |
| Gallocatechin gallate | Escherichia coli O157:H7; Escherichia coli; Pseudomonas aeruginosa | Verotoxin; Cellular defense protein; Antibacterial Susceptibility | [15,16,17] |
| Catechin | Escherichia coli O157:H7 | Verotoxin | [15] |
| Epigallocatechin gallate | Escherichia coli; Pseudomonas aeruginosa; Escherichia coli; Gram-positive bacteria; Escherichia coli; Bacillus subtilis; E. coli MG1655; Pseudomonas fluorescens; Staphylococcus aureus | Cellular defense protein; Antibacterial Susceptibility; Antibacterial Susceptibility; Bacterial membrane; H2O2; Cell surface proteins; Hfq protein; Extra-cytoplasmic function sigma factor, Histidine kinase; Membrane transport | [16,17,18,19,21,22,23,24,25] |
| Epicatechin gallate | Escherichia coli O157:H7; Escherichia coli; Pseudomonas aeruginosa; Escherichia coli; Escherichia coli; Staphylococcus aureus | Vero toxin; Cellular defense protein; Antibacterial Susceptibility; H2O2; β-lactam resistance | [15,16,17,18,21,26] |
Publisher’s Note: MDPI stays neutral with regard to jurisdictional claims in published maps and institutional affiliations. |
© 2021 by the authors. Licensee MDPI, Basel, Switzerland. This article is an open access article distributed under the terms and conditions of the Creative Commons Attribution (CC BY) license (https://creativecommons.org/licenses/by/4.0/).
Share and Cite
Kim, J.-W.; Kim, C.-Y.; Kim, J.-H.; Jeong, J.-S.; Lim, J.-O.; Ko, J.-W.; Kim, T.-W. Prophylactic Catechin-Rich Green Tea Extract Treatment Ameliorates Pathogenic Enterotoxic Escherichia coli-Induced Colitis. Pathogens 2021, 10, 1573. https://doi.org/10.3390/pathogens10121573
Kim J-W, Kim C-Y, Kim J-H, Jeong J-S, Lim J-O, Ko J-W, Kim T-W. Prophylactic Catechin-Rich Green Tea Extract Treatment Ameliorates Pathogenic Enterotoxic Escherichia coli-Induced Colitis. Pathogens. 2021; 10(12):1573. https://doi.org/10.3390/pathogens10121573
Chicago/Turabian StyleKim, Jeong-Won, Chang-Yeop Kim, Jin-Hwa Kim, Ji-Soo Jeong, Je-Oh Lim, Je-Won Ko, and Tae-Won Kim. 2021. "Prophylactic Catechin-Rich Green Tea Extract Treatment Ameliorates Pathogenic Enterotoxic Escherichia coli-Induced Colitis" Pathogens 10, no. 12: 1573. https://doi.org/10.3390/pathogens10121573
APA StyleKim, J.-W., Kim, C.-Y., Kim, J.-H., Jeong, J.-S., Lim, J.-O., Ko, J.-W., & Kim, T.-W. (2021). Prophylactic Catechin-Rich Green Tea Extract Treatment Ameliorates Pathogenic Enterotoxic Escherichia coli-Induced Colitis. Pathogens, 10(12), 1573. https://doi.org/10.3390/pathogens10121573

